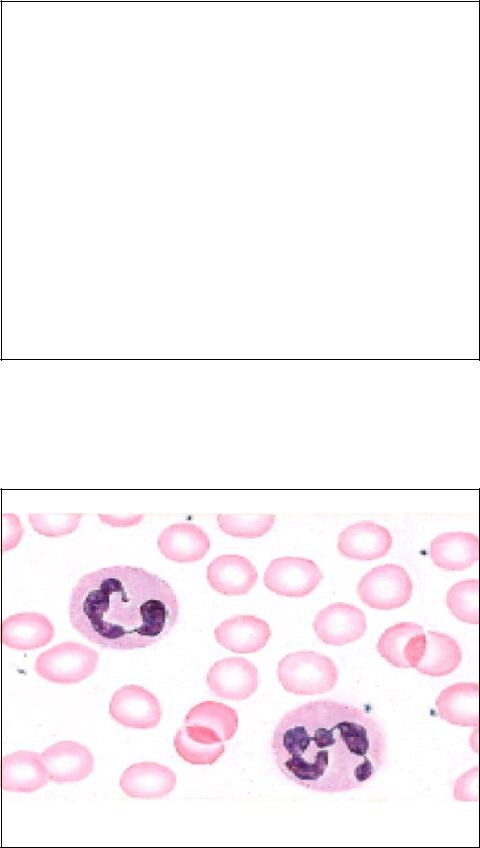
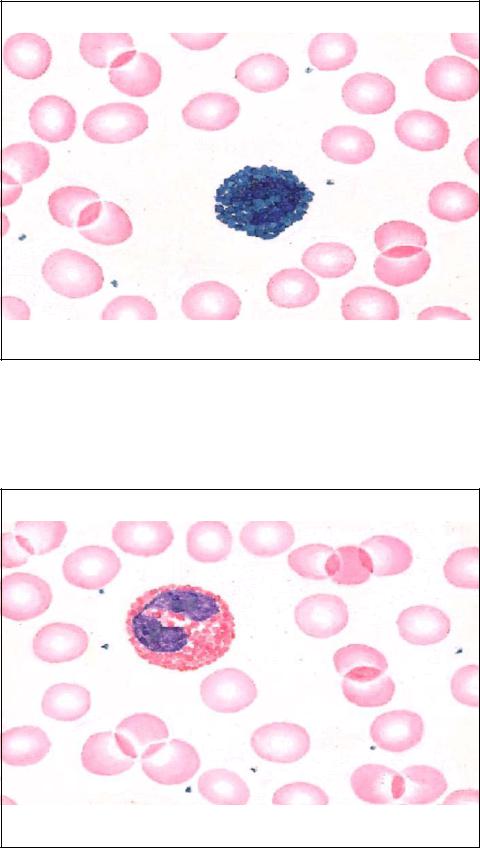

2 курс / Гистология / Кровь_Гистология_форменных_элементов_крови
.pdf
КЛИНИЧЕСКИЕ КОРРЕЛЯЦИИ
В ответ на появление ряда антигенов плазмациты выделяют IgE. Fc фрагмент молекулы IgE присоединяется к рецепторам базофила без всякого эффекта. Но в следующий раз при попадании в организм того же антигена, он привязывается к молекуле IgE на поверхности базофила.
1.Связывание антигена с молекулой IgE на поверхности базофила (или тучной клетки) вызывает высвобождение содержимого гранул базофила во внеклеточное пространство. 2.Кроме того, фосфолипазы гранул действуют на определенные фосфолипиды плазмалеммы базофила с образованием арахидоновой кислоты. Арахидорновая кислота метаболизируется с образованием лейкотриенов C4,D4 и E4.
3.Высвобождение гистамина вызывает вазодилатацию, сокращение гладкой мускулатуры бронхов и увеличение проницаемости сосудов.
4.Лейкотриены имеют сходный эффект, но действуют они медленнее и продолжительнее, чем гистамин. Кроме того, лейкотриены активируют лейкоциты, заставляя их мигрировать
в очаг аллергической реакции. |
81 |
гранулоциты
|
признак |
нейтрофил |
эозинофил |
базофил |
|
|||
|
|
|
|
|
|
|
|
|
|
число/мм3 |
3500-7000 |
150-400 |
|
|
50-100 |
|
|
|
% лейкоцитов |
45-70 % |
1-5 % |
|
|
< 1 % |
|
|
|
диаметр (мкм) |
8-9 |
|
9-11 |
|
|
7-8 |
|
|
(срез) (мазок) |
9-12 |
|
10-14 |
|
|
8-10 |
|
|
ядро |
3-4 доли |
2 доли |
|
|
S-образное |
|
|
|
|
|
|
|
|
|
||
|
Специфические |
0.1 |
мкм, |
1-1.5 мкм темно-розовые |
0.5 мкм синие |
|
||
|
гранулы |
светло- |
|
|
|
|
|
|
|
|
розовые |
|
|
|
|
|
|
|
Содержимое |
тип |
IV |
Арил |
сульфатаза, |
Гистамин, |
|
|
|
специфических |
коллагена- |
гистаминаза, |
бета- |
гепарин, |
|
||
|
гранул |
зы, |
фосфо- |
глюкуронидаза, |
кислая |
эозинофильный |
|
|
|
|
липаза A, |
фосфатаза, фосфолипаза, |
хемотаксический |
|
|||
|
|
лактофер- |
главный |
|
основной |
фактор, |
|
|
|
|
рин, |
лизо- |
белок, |
эозинофильный |
нейтрофильный |
|
|
|
|
цим, |
фаго- |
катионный |
белок, |
хемотаксический |
|
|
|
|
цитин, |
нейротоксин, |
РНКаза, |
фактор, |
|
||
|
|
щелочная |
катепсин, пероксидаза |
82 |
|
|||
|
|
пероксидаза |
|
|||||
|
|
фосфатаза |
|
|
|
|
|
|
41

Гранулоциты
признак |
нейтрофил |
эозинофил |
|
базофил |
|
||
|
|
|
|
|
|
||
поверх- |
Fc |
рецепторы, |
рецепторы IgE, |
Рецепторы IgE |
|
||
ностный |
рецептор |
тромбицит- |
рецептор |
|
|
|
|
маркер |
активирующего |
эозинофиль- |
|
|
|
||
|
фактора, |
|
рецептор |
ного |
|
|
|
|
лейкотриена |
B4, |
хемотаксическо |
|
|
|
|
|
лейкоцитарная |
го фактора |
|
|
|
||
|
адгезионная |
|
|
|
|
|
|
|
молекула-1 |
|
|
|
|
|
|
продолжите |
< 1 недели |
|
< 2 недель |
1-2 |
года |
(у |
|
льность |
|
|
|
|
животных) |
|
|
жизни |
|
|
|
|
|
|
|
функции |
Фагоцитоз |
и |
Фагоцитоз |
Медиирование |
|
||
|
разрушение бактерий |
иммунных |
воспалительных |
||||
|
|
|
|
комплексов, |
реакций, как |
у |
|
|
|
|
|
деструкция |
тучных клеток |
|
|
|
|
|
|
паразитов |
|
|
|
|
|
|
|
|
|
83 |
|
Лимфоциты - это мелкие клетки диаметром 8-10 микрометров с единственным округлым эксцентричным ядром (N), окруженным узким ободком цитоплазмы (головка стрелки). Ядро очень плотное с большим количеством гетерохроматина. В цитоплазме присутствуют азурофильные гранулы. По размерам лимфоциты делятся на малые (самые дифференцированные), средние (1215 мкм) и большие (15-18 мкм – это бластные формы. Лимфоциты присутствуют в небольших количествах в соединительной ткани, но в очагах хронического воспаления их присутствует множество. Лимфоциты - это единственные из лейкоцитов, возвращающиеся в кровоток после того, как покинут его. Они участвуют в иммунном ответе, имеют слабую фагоцитарную активность.
Лимфоцит.
x 1325.
N
42

Нулевые клетки
Лимфоцит, ТЭМ, x10,000 включают две различные популяции:
- циркулирующие
стволовые клетки, дающие начало всем клеткам периферической крови, - естественные
киллеры (NKклетки), которые могут убивать чужеродные клетки и клетки, инфицированные вирусами, без участия Т-клеток.
85
На электронной микрофотографии видно, что в небольшом объеме цитоплазмы находятся немного митохондрий, мелкий комплекс Гольджи, немного профилей ГЭС. Имеются азурофильные гранулы (лизосомы) и много свободных рибосом. Выделяют 3 типа лимфоцитов: Т-лимфоциты. В- лимфоциты и нулевые клетки. Идентифицировать морфологически их невозможно
– лишь иммуногистохимически с
определением |
типа |
|
поверхностных |
маркеров |
|
(кластеров |
дифференцировки |
|
CD). |
Примерно |
80% |
циркулирующих лимфоцитов – это Т-клетки. 15% - В-клетки и остальные – нулевые клетки. Продолжительность их жизни варьирует от многих лет (Т-
клетки) до месяцев (В-клетки).LYMPHOCYTE, TEM
43

|
|
|
Лимфоциты |
не |
|
несут |
|||
|
|
специфических функций в кровотоке. |
|||||||
|
|
Им надо попасть в соединительную |
|||||||
|
|
ткань |
для |
реализации |
|
функции |
|||
|
|
иммунной защиты. Для того, чтобы |
|||||||
|
|
стать |
иммунокомпетентными, |
клетки |
|||||
|
|
должны мигрировать в определенные |
|||||||
|
|
компартменты |
иммунной |
|
системы. |
||||
|
|
Чтобы |
|
созреть |
и |
приобрести |
|||
|
|
экспрессии |
|
специфических |
|||||
|
|
поверхностных маркеров и рецепторы. |
|||||||
|
|
|
В-клетки заходят в еще не |
||||||
|
|
идентифицированные |
|
|
участки |
||||
|
|
красного костного мозга, |
в то время |
||||||
Средний лимфоцит, ТЭМ |
как Т-клетки мигрируют в |
корковое |
|||||||
|
|
вещество |
|
тимуса. |
|
|
Став |
||
|
|
иммунокомпетентными, |
|
|
клетки |
||||
После |
стимуляции |
покидают |
данный |
компартмент, |
|||||
попадают |
в |
иммунную |
|
систему, |
|||||
специфическим антигеном и Т-, |
делятся |
митозом, |
формируя |
клон |
|||||
и В-лимфоциты пролифери- |
идентичных клеток. Все клетки данного |
||||||||
руют и дифференцируются на |
клона могут распознавать один и тот |
||||||||
две популяции: |
эффекторные |
же тип антигена и формировать ответ |
|||||||
клетки и клетки памяти. |
на его попадание. |
|
|
87 |
|||||
|
|
|
|
||||||
|
|
|
|
|
|
|
|
|
|
ВИДЫ ЛИМФОЦИТОВ
1.Клетки памяти не участвуют в иммунном ответе, но сохраняются как часть клона, наделенная иммунологической памятью, готовая запустить иммунный ответ против повторно попадающего в организм корпускулярного антигена или чужеродного вещества.
2.Эффекторные клетки классифицируются на Т- и В-лимфоциты (и их подтипы). Это иммунокомпетентные клетки, которые несут иммунные функции, например, функцию элиминации антигена. B- лимфоциты ответственны за гуморальный иммунный ответ, а именно: они дифференцируются в плазмоциты, которые продуцируют антитела против антигенов. Т-лимфоциты отвечают за клеточный иммунный ответ. Некоторые Т-лимфоциты дифференцируются в цитотоксические клетки (Т-киллеры), которые вступают в физический контакт с чужеродными или инфицированными вирусом клетками и уничтожают их. Кроме того, определенные Т-клетки ответственны за инициирование и развитие (Т-хелперы) или подавление (Т-суппрессоры) большинства клеточных или гуморальных иммунных реакций. Они осуществляют эти функции с помощью сигнальных молекул (цитокинов, а именно
–лимфокинов), которые вызывают определенный ответ со
стороны других клеток иммунной системы. |
88 |
|
44

ФУНКЦИОНАЛЬНЫЕ КОРРЕЛЯЦИИ
CD8+клетки (цитотоксические и супрессоры) распознают антиген, содержат главный цитотоксический белок – перфорин). Каждый клон Т-лимфоцитов производит и содержит один вид специфического рецептора для взаимодействия с одним антигеном.
На поверхности несет сотни молекул специфических иммуноглобулинов (много меньше, чем В-лимфоциты, у которых молекулы Ig (на 2/3 это IgM) исчисляются сотнями тысяч.
CD4+ клетки-хелперы. Поддерживают пролиферацию В-клеток и секрецию ими Ig. Секретируют интерлейкин 3, GM-CSF, TNF альфа
Тh2 хелперы поддерживают секрецию IgE, вырабатывают интерлейкины 4,5.
Th1 стимулируют образование цитотоксических лимфоцитов, поддерживают пролиферацию и дифференцировку Т-супрессоров, секретируют интерлейкин 2, TNF бета, ИФН.
NK – клетки без поверхностных детерминант, также содержат перфорины.
B-клетки реализуют гуморальный иммунный ответ (выработку антител).
89
МОНОЦИТ |
В |
|
МАЗКЕ |
|
|||
КРОВИ. x 1325. |
|
|
|
|
|
||
Моноциты |
– |
|
самые |
|
|||
крупные |
|
|
из |
|
клеток |
|
|
циркулирующей |
|
крови |
с |
g |
|||
диаметром 12-15 мкм. У них |
|
||||||
много серо-голубой цитоплазмы, |
|
||||||
содержащей |
|
|
|
много |
h |
||
азурофильных гранул, в то |
|
||||||
время |
как |
специфические |
N |
||||
гранулы |
|
отсутствуют. |
|
Ядро |
|||
бобовидной |
формы |
с |
рыхлым |
|
|||
хроматином, в котором видны |
|
||||||
обширные |
|
|
|
|
светлые |
|
|
пространства. |
Доли |
|
ядра |
|
|||
накладываются друг на друга, |
|
||||||
иногда даже трудно проследить |
|
||||||
их контуры. Моноциты остаются |
|
||||||
в кровотоке несколько дней, |
|
||||||
после чего они мигрируют в |
|
||||||
соединительную ткань, где они |
|
||||||
дифференцируются |
|
|
в |
|
|||
макрофаги. |
|
|
|
|
|
|
|
|
|
|
|
|
|
|
|
45

Моноциты имеют крупное эксцентричное бобовидное ядро, которое часто имеет контуры как «молью изъеденные» с выростами в виде долей, перекрывающих друг друга. Хроматин достаточно рыхлый, присутствует как гетеро, так и эухроматин с преобладанием последнего. Нередко присутствует два ядрышка, не всегда различимые в мазках крови. В цитоплазме встречаются гранулы гликогена, немного профилей ГЭС, митохондрий (М) и свободных рибосом (R), а также множество лизосом. На периферии клетки видны микротрубочки, микрофиламенты, пиноцитозные пузырьки и филоподии. Макрофаги фагоцитируют нежелательные частицы, производят цитокины, требующиеся для иммунного ответа, и представляют эпитопы антигенов Т-лимфоцитам.
МОНОЦИТ, ТЭМ
91
ФУНКЦИИМАКРОФАГОВ 1.Макрофаги – это облигатные фагоциты, они входят в систему
мононуклеарных фагоцитов, которые фагоцитируют мертвые и дефектные клетки (стареющие эритроциты), а также антигены и чужеродные частицы (например, бактериальные). Эта деструкция происходит в фагосомах через ферментное переваривание или образование активных форм кислорода: супероксиданиона. Перекиси водорода и проч.
2.Макрофаги продуцируют цитокины, которые активируют воспалительный ответ, а также пролиферацию и созревание других клеток.
3.Некоторые макрофагальные клетки являются антигенпрезентирующими. Они фагоцитируют антигены и представляют их самые антигенные части – эпитопы – вместе с интегральными белками, человеческими лейкоцитарными антигенами II класса (известного также как антиген главного комплекса гистосовместимости II класса) – иммунокомпетентным клеткам.
4.В ответ на попадание крупной чужеродной частицы макрофаги сливаются образуя гигантскую клетку инородных тел, которая достаточно велика для поглощения данной чужеродной частицы.
92
46

АГРАНУЛОЦИТЫ
признак |
лимфоцит |
моноцит |
|
||
|
|
|
|
|
|
число/мм3 |
1500-2500 |
|
200-800 |
|
|
% лейкоцитов |
20-35 % |
|
3-9 % |
|
|
диаметр (мкм) |
7-8 |
|
10-12 |
|
|
(срез) (мазок) |
8-10 |
|
12-15 |
|
|
ядро |
круглое |
|
бобовидное |
|
|
Специф.гранулы |
нет |
|
нет |
|
|
Поверхностные |
T-клетки: T- клеточные |
класс II HLA, |
|
|
|
маркеры |
рецепторы, CDмолекулы, IL |
Fc рецепторы |
|
|
|
|
рецепторы |
|
|
|
|
|
B-клетки |
поверхностные |
|
|
|
|
иммуноглобулины |
|
|
|
|
Продолжитель- |
Месяцы-годы |
Дни в крови, месяцы в |
|||
ность жизни |
|
|
соединительной ткани |
|
|
функции |
T-клетки: |
клеточный |
дифференцировка |
в |
|
|
иммунный ответ |
макрофаги, |
фагоцитоз, |
||
|
B-клетки: |
гуморальный |
презентация антигенов |
|
|
|
иммунный ответ |
|
93 |
|
|
ВОЗРАСТНЫЕ ИЗМЕНЕНИЯ ЛЕЙКОЦИТАРНОЙФОРМУЛЫ
Физиологические перекресты:
1.При рождении соотношение лимфоцитов и нейтрофилов, как увзрослых.
2.Затем доля нейтрофилов падает, а лимфоцитов возрастает, к
3-4 суткам они сравниваются (1-ый физиологический перекрест).
3.Далее % нейтрофилов падает еще больше, алимфоцитов еще больше возрастает, к 1-2 годам нейтрофилы 25%, лимфоциты - 65%
4.2-ой физиологический перекрест: с 2-х лет опять доля нейтрофилов возрастает, лимфоцитов - падает, к 4-м годам они сравниваются.
5.Далее % нейтрофилов продолжают возрастать, лимфоцитов - продолжает падать, и к половомусозреванию значения
нормализуются (как увзрослых).
94
47
ВОЗРАСТНЫЕ ИЗМЕНЕНИЯ ГЕМОГРАММЫ
I. Эритроциты:
1.При рождении число их6-7 х 1012
2.К 10-14 суткам число снижается до нормальных значений взрослого.
3.Продолжает снижаться до 3-6 мес (физиологическая анемия, так синтез эритропоэтинов перемещается из печени в почку в связи с прекращением кроветворной функции печени.
4.К половому созреванию восстанавливается нормальное значение содержания эритроцитов.
II. Лейкоциты:
1.У новорожденных лейкоцитоз до 10-13х109
2.Первые 2 недели – снижение до 9-15х109
3.К 14 годам значение нормализуется (как увзрослых).
95
96
48
97
98
49

99
100
50
